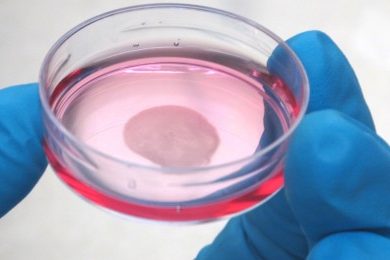

บทความ พร้อม ภาพถ่ายงานวิจัย ภาพถ่ายอาจารย์ หรือนักศึกษาเจ้าของผลงาน
งานวิจัยนี้ได้นำเซลล์กระดูกอ่อนบริเวณข้อเข่าของผู้ป่วยที่แพทย์วินิจฉัยว่าต้องตัดเข่าทิ้งมาแยกเอาเซลล์กระดูกอ่อน แล้วนำเซลล์เหล่านี้ไปเพิ่มจำนวนในห้องปฏิบัติการให้มากพอ จากนั้นจึงนำไปสร้างเป็นแผ่นเซลล์กระดูกอ่อนด้วยเทคโนโลยีแผ่นเซลล์
เปิดตัวอย่างเป็นทางการ “EATLAB” บริษัท Deep Tech Startup ที่ spin-off จากมหาวิทยาลัยเทคโนโลยีพระจอมเกล้าธนบุรี กับการเปิดร้านอาหารอย่างเป็นทางการ แห่งแรกที่บันทึกพฤติกรรมการรับประทานอาหารของผู้บริโภคในยุค 4.0
ทุกปีมีประชากรมากถึง 1,600 คน เสียชีวิตเนื่องจากอุบัติเหตุลื่นล้ม ผู้เสียชีวิตส่วนใหญ่เป็นผู้สูงอายุที่มีอายุมากกว่า 60 ปี และการเสียชีวิตจากการลื่นล้มมีอัตราเพิ่มขึ้นอย่างต่อเนื่อง จากปัญหานี้ทำให้ ทีม ดิ การ์เดียน พัฒนาผลงานนวัตกรรม “ระบบเฝ้าระวังอัจฉริยะสาหรับผู้สูงอายุและคนพิการโปรแกรมเพื่อช่วยคนพิการและผู้สูงอายุ” เพื่อตอบโจทย์ปัญหาสังคมผู้อายุ
ความสำคัญของ “ความเท่าเทียมของคนทั้งมวล” ทำให้นางสาวขวัญชนก ตั้งศรีวงศ์ และนายธนชัย เจริญวัฒนกิจ เกิดแนวคิดในการช่วยคนพิการและผู้สูงอายุที่ใช้วีลแชร์เดินทางสะดวกขึ้น พร้อมกับได้ออกกำลังกายและกายภาพบำบัดในเวลาเดียวกัน
นายพัชรวจี ดวงแก้ว และนางสาวณีรนุช รักยิ่ง สองนักศึกษา และดร.นุจริน จงรุจา อาจารย์ประจำภาควิชาจุลชีววิทยา ทีมวิจัยคณะวิทยาศาสตร์ ค้นพบสารยับยั้งจุลินทรีย์กับเชื้อแบคทีเรียและเชื้อก่อโรคบนผิวหนัง ทดแทนการใช้ยาปฏิชีวนะ